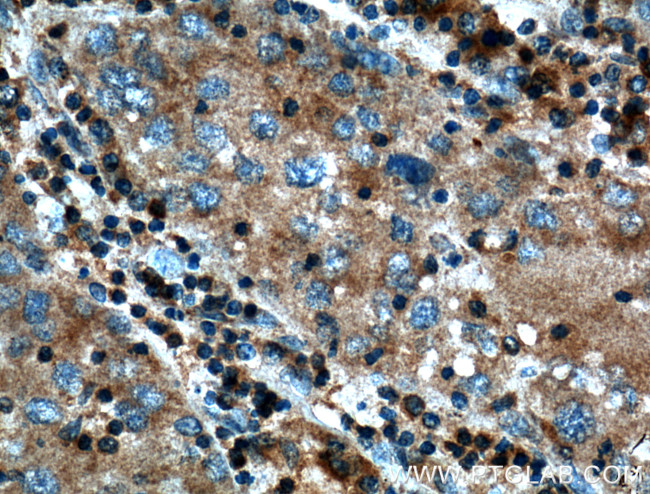
SAMD8 Antibody in Immunohistochemistry (Paraffin) (IHC (P))

Search
Proteintech
SAMD8 Polyclonal Antibody
{{$productOrderCtrl.translations['antibody.pdp.commerceCard.promotion.promotions']}}
{{$productOrderCtrl.translations['antibody.pdp.commerceCard.promotion.viewpromo']}}
{{$productOrderCtrl.translations['antibody.pdp.commerceCard.promotion.promocode']}}: {{promo.promoCode}} {{promo.promoTitle}} {{promo.promoDescription}}. {{$productOrderCtrl.translations['antibody.pdp.commerceCard.promotion.learnmore']}}
产品信息
26815-1-AP
种属反应
宿主/亚型
分类
类型
抗原
偶联物
形式
浓度
规格
纯化类型
保存液
内含物
保存条件
运输条件
产品详细信息
Immunogen sequence: MAGPNQLCI RRWTTKHVAV WLKDEGFFEY VDILCNKHRL DGITLLTLTE YDLRSPPLEI KVLGDIKRLM LSVRKLQKIH IDVLEEMGYN SDSPMGSMTP FISALQSTDW LCNGELSHDC DGPITDLNSD QYQYMNGKNK HSVRRLDPEY WKT (1-152 aa encoded by BC146556)
靶标信息
Sphingomyelin synthases synthesize sphingolipids through transfer of a phosphatidyl head group on to the primary hydroxyl of ceramide. SAMD8 is an endoplasmic reticulum (ER) transferase that has no sphingomyelin synthase activity but can convert phosphatidylethanolamine (PE) and ceramide to ceramide phosphoethanolamine (CPE) albeit with low product yield. Appears to operate as a ceramide sensor to control ceramide homeostasis in the endoplasmic reticulum rather than a converter of ceramides. Seems to be critical for the integrity of the early secretory pathway. [UniProt]
仅用于科研。不用于诊断过程。未经明确授权不得转售。
篇参考文献 (0)
生物信息学
蛋白别名: Ceramide phosphoethanolamine synthase; CPE synthase; epididymis luminal protein 177; epididymis secretory sperm binding protein Li 181mP; FLJ25082; HEL-S-181mP; PE-PLC; Phosphatidylethanolamine Phospholipase C; RP11-487I5.5; SAM domain-containing protein 8; SMSr; sphingomyelin synthase related; Sphingomyelin synthase-related protein 1; Sterile alpha motif domain-containing protein 8; unnamed protein product
基因别名: HEL-177; SAMD8; SMSr
UniProt ID: (Human) Q96LT4
Entrez Gene ID: (Human) 142891